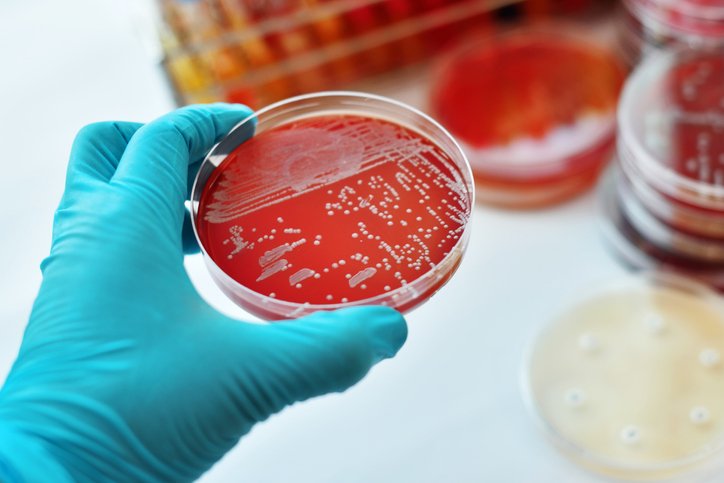

고정 헤더 영역
상세 컨텐츠
본문
신종 코로나바이러스는 단순한 감기몸살이 아닌 폐렴을 일으킨다고 합니다. 그렇다면 폐렴과 비슷한 증상의 감기와는 어떤 점에서 차이가 있는지 감기와 폐렴 증상의 차이점부터 폐렴 예방법을 알아보도록 하겠습니다.
폐렴 원인과 증상
폐렴은 폐에 염증이 생기는 질환으로 세균, 바이러스, 곰팡이 등 발생 원인이 다양합니다. 보통 발열, 가래, 기침 등 감기와 초기 증상이 비슷한 탓에 감기로 오인해 치료 시기가 늦어지는 경우가 많습니다.
하지만 감기와 폐렴 증상에는 큰 차이가 몇 가지 있습니다. 폐렴은 호흡기는 물론이고 가슴 통증, 호흡곤란, 두통, 근육통 등 전신에 증상이 나타납니다. 또 발열, 기침, 가래, 신음, 수유 부전 등 호흡기계 증상과 감염의 이차적인 증상인 황달, 피부 반점 등이 생길 수 있습니다.

또한 기침과 함께 오한과 발열을 보이거나 식욕이 떨어지고 평소와 달리 잘 놀지 않을 때도 단순한 감기보다는 폐렴일 가능성이 높습니다. 따라서 호흡기는 물론 전신에 여러 가지 증상이 동반되는 경우 병원을 찾아 폐렴 여부를 확인해야 합니다.
폐렴은 원인균에 따라 치료
폐렴은 원인균에 따라 치료하며 보통 입원 치료를 하는 경우가 대부분이지만 그렇다고 무조건 입원이 필요한 건 아닙니다. 심하지 않은 경우엔 아이를 안정시키고 충분한 수분 섭취와 적절한 영양을 공급하는 게 중요합니다. 만약 기침이 심하다면 이를 완화하는 약을 복용하는 것도 방법입니다.

인플루엔자 바이러스로 인한 폐렴은 병원에서 바이러스를 없애는 약을 처방받아 치료하면 됩니다. 대부분 소아 폐렴은 치료가 가능한 편이고 짧은 입원 치료로도 호전되니 크게 걱정할 필요는 없습니다. 다만 생후 6~24개월 아이는 열성 경련이 나타날 수 있으니 발열 상태를 세심히 살펴야 합니다.
폐렴 후유증
병의 종류에 따라 다른데, 바이러스 성은 약하게 지나갈 수 있으나, 세균성인 경우에는 급성으로 심하게 경과하고 합병증도 많으며, 선천성 자궁내 감염에 의한경우에는 만성이며, 다른 합병증도 잘 동반합니다.
세균성 감염인 경우에는 패혈증을 잘 동반하고, 선천성 자궁내 감염인 경우에는 심장, 머리 등의 기형을 동반할 수 있습니다.
소아 폐렴은 위생 관리가 중요

소아 폐렴은 한 번 걸리면 쉽게 다시 감염될 수 있습니다. 만성으로 이어질 확률이 높으므로 조기에 예방하는 게 필수입니다. 겨울엔 폐렴 바이러스가 활동하기 좋은 환경이므로 개인위생에 특히 신경 써야 합니다.
어린아이는 면역력이 약해 질병에 쉽게 전염되므로 증상이 있는 아이들과 접촉을 피하는 게 가장 확실한 예방법입니다. 손을 깨끗이 자주 씻는 습관을 들이고 충분한 수면과 균형적인 영양 섭취를 해야 하며, 목욕 후에는 체온 조절 기능이 떨어지니 재빨리 물기를 닦아줘야 합니다. 또한 실내가 건조하지 않도록 습도는 40~60%, 온도는 20~22℃를 유지합니다.
소아 폐렴에 좋은 음식

피를 깨끗하게 해 혈액순환에 좋고 서늘한 성질을 가지고 있어 소아폐렴으로 인해 열이 날 경우 열을 식혀주는 역할을 하는 미나리가 좋습니다. 또, 목을 시원하게 해고 기침과 가래를 멎게하는 효과가 있는 배가 있으며, 사포닌 성분이 풍부해 기침과 가래를 가라앉히고 폐를 맑게해주는 등 호흡기질환에 좋은 도라지도 있습니다.

이외 호박은 유해산소를 배출하고 비타민 C가 풍부해 면역력 향상에 도움을 주며 기관지 점막을 튼튼하게 해주고, 무는 폐를 따뜻하게 달래주고 소화 효소가 풍부하며 기침을 멎게 해줍니다. 마지막으로 감은 몸을 삭히고 폐를 보호하는 성질을 가지고 있습니다.
사진 게티이미지뱅크
'건강&다이어트' 카테고리의 다른 글
| 우울증 치료에 탁월한 '우엉' (+요리 및 보관법) (0) | 2021.01.27 |
|---|---|
| 위생만으로 '호흡기 질환 '예방 가능 (+기침완화방법,만들기) (0) | 2021.01.26 |
| 겨울철 면역력 향상에 도움이 되는 음식 5가지(+면역력이 떨어지는 이유) (0) | 2021.01.25 |
| 피부 건강 망치고 있는 잘못된 세안법 (+올바른 세안법) (0) | 2021.01.25 |
| 다이어트에 닭가슴살? 더 좋은 '이것'의 정체 (+효능) (0) | 2021.01.22 |





댓글 영역